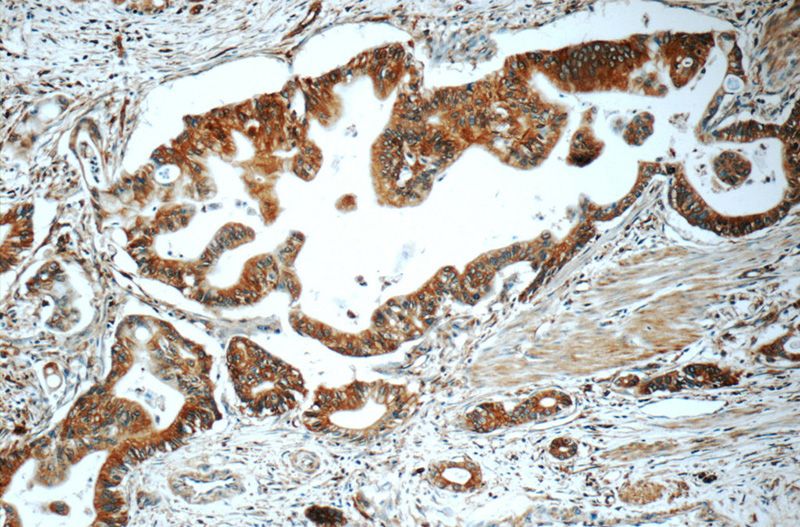
Immunohistochemistry of paraffin-embedded human pancreas cancer tissue slide using Catalog No:115850(TAP1 Antibody) at dilution of 1:50 (under 10x lens)
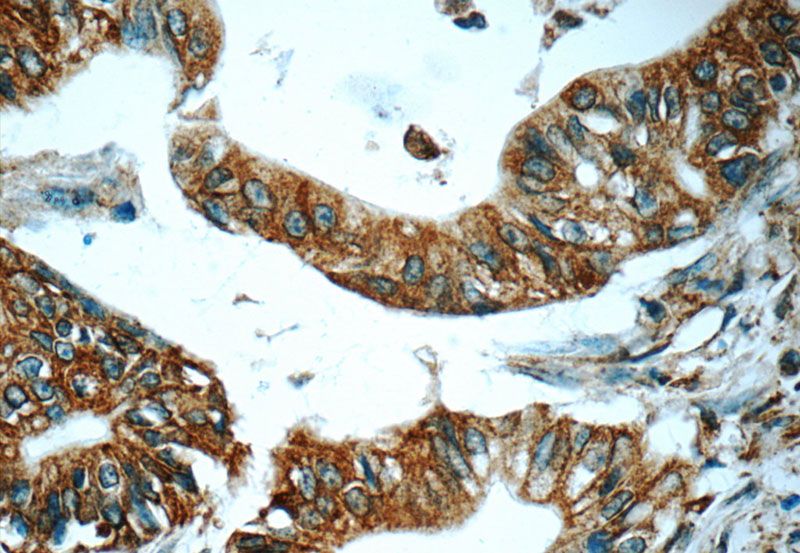
Immunohistochemistry of paraffin-embedded human pancreas cancer tissue slide using Catalog No:115850(TAP1 Antibody) at dilution of 1:50 (under 40x lens)

-
Product Name
TAP1 antibody
- Documents
-
Description
TAP1 Rabbit Polyclonal antibody. Positive IHC detected in human pancreas cancer tissue, HeLa cells, human lung cancer tissue. Positive IF detected in HepG2 cells. Positive WB detected in HepG2 cells, human skeletal muscle tissue, mouse skeletal muscle tissue, mouse spleen tissue, Raji cells. Positive IP detected in HepG2 cells. Observed molecular weight by Western-blot: 70-81 kDa
-
Tested applications
ELISA, IF, WB, IHC, IP
-
Species reactivity
Human,Mouse,Rat; other species not tested.
-
Alternative names
ABCB2 antibody; Antigen peptide transporter 1 antibody; PSF 1 antibody; RING 4 antibody; RING4 antibody; TAP1 antibody
-
Isotype
Rabbit IgG
-
Preparation
This antibody was obtained by immunization of TAP1 recombinant protein (Accession Number: BC014081). Purification method: Antigen affinity purified.
-
Clonality
Polyclonal
-
Formulation
PBS with 0.1% sodium azide and 50% glycerol pH 7.3.
-
Storage instructions
Store at -20℃. DO NOT ALIQUOT
-
Applications
Recommended Dilution:
WB: 1:500-1:5000
IP: 1:200-1:2000
IHC: 1:20-1:200
IF: 1:20-1:200
-
Validations

HepG2 cells were subjected to SDS PAGE followed by western blot with Catalog No:115850(TAP1 Antibody) at dilution of 1:1000

Immunofluorescent analysis of HepG2 cells, using TAP1 antibody Catalog No:115850 at 1:50 dilution and Rhodamine-labeled goat anti-rabbit IgG (red). Blue pseudocolor = DAPI (fluorescent DNA dye).

IP Result of anti-TAP1 (IP:Catalog No:115850, 4ug; Detection:Catalog No:115850 1:500) with HepG2 cells lysate 2400ug.
Immunohistochemistry of paraffin-embedded human pancreas cancer tissue slide using Catalog No:115850(TAP1 Antibody) at dilution of 1:50 (under 10x lens)
Immunohistochemistry of paraffin-embedded human pancreas cancer tissue slide using Catalog No:115850(TAP1 Antibody) at dilution of 1:50 (under 40x lens)
-
Background
TAP1, also known as ABCB2, PSF1 or RING4, is a member of the ATP-binding cassette (ABC) family of transmembrane transporters and is an essential component of the major histocompatability complex (MHC) class I antigen-presenting pathway. TAP is involved in the transport of antigens from the cytoplasm to the endoplasmic reticulum for association with MHC class I molecules. It also acts as a molecular scaffold for the final stage of MHC class I folding. Defects in TAP1 are a cause of bare lymphocyte syndrome type 1 (BLS1). Western blot analysis using this antibody detected a major band around 70-80kD in HeLa cells.
-
References
- Kasajima A, Sers C, Sasano H. Down-regulation of the antigen processing machinery is linked to a loss of inflammatory response in colorectal cancer. Human pathology. 41(12):1758-69. 2010.
- Qifeng S, Bo C, Xingtao J, Chuanliang P, Xiaogang Z. Methylation of the promoter of human leukocyte antigen class I in human esophageal squamous cell carcinoma and its histopathological characteristics. The Journal of thoracic and cardiovascular surgery. 141(3):808-14. 2011.
- Bartoszewski R, Brewer JW, Rab A. The unfolded protein response (UPR)-activated transcription factor X-box-binding protein 1 (XBP1) induces microRNA-346 expression that targets the human antigen peptide transporter 1 (TAP1) mRNA and governs immune regulatory genes. The Journal of biological chemistry. 286(48):41862-70. 2011.
- Zhao X, Sun Q, Tian H, Cong B, Jiang X, Peng C. Loss of heterozygosity at 6p21 and HLA class I expression in esophageal squamous cell carcinomas in China. Asian Pacific journal of cancer prevention : APJCP. 12(10):2741-5. 2011.
- Zufferey A, Schvartz D, Nolli S, Reny JL, Sanchez JC, Fontana P. Characterization of the platelet granule proteome: evidence of the presence of MHC1 in alpha-granules. Journal of proteomics. 101:130-40. 2014.
Related Products / Services
Please note: All products are "FOR RESEARCH USE ONLY AND ARE NOT INTENDED FOR DIAGNOSTIC OR THERAPEUTIC USE"
